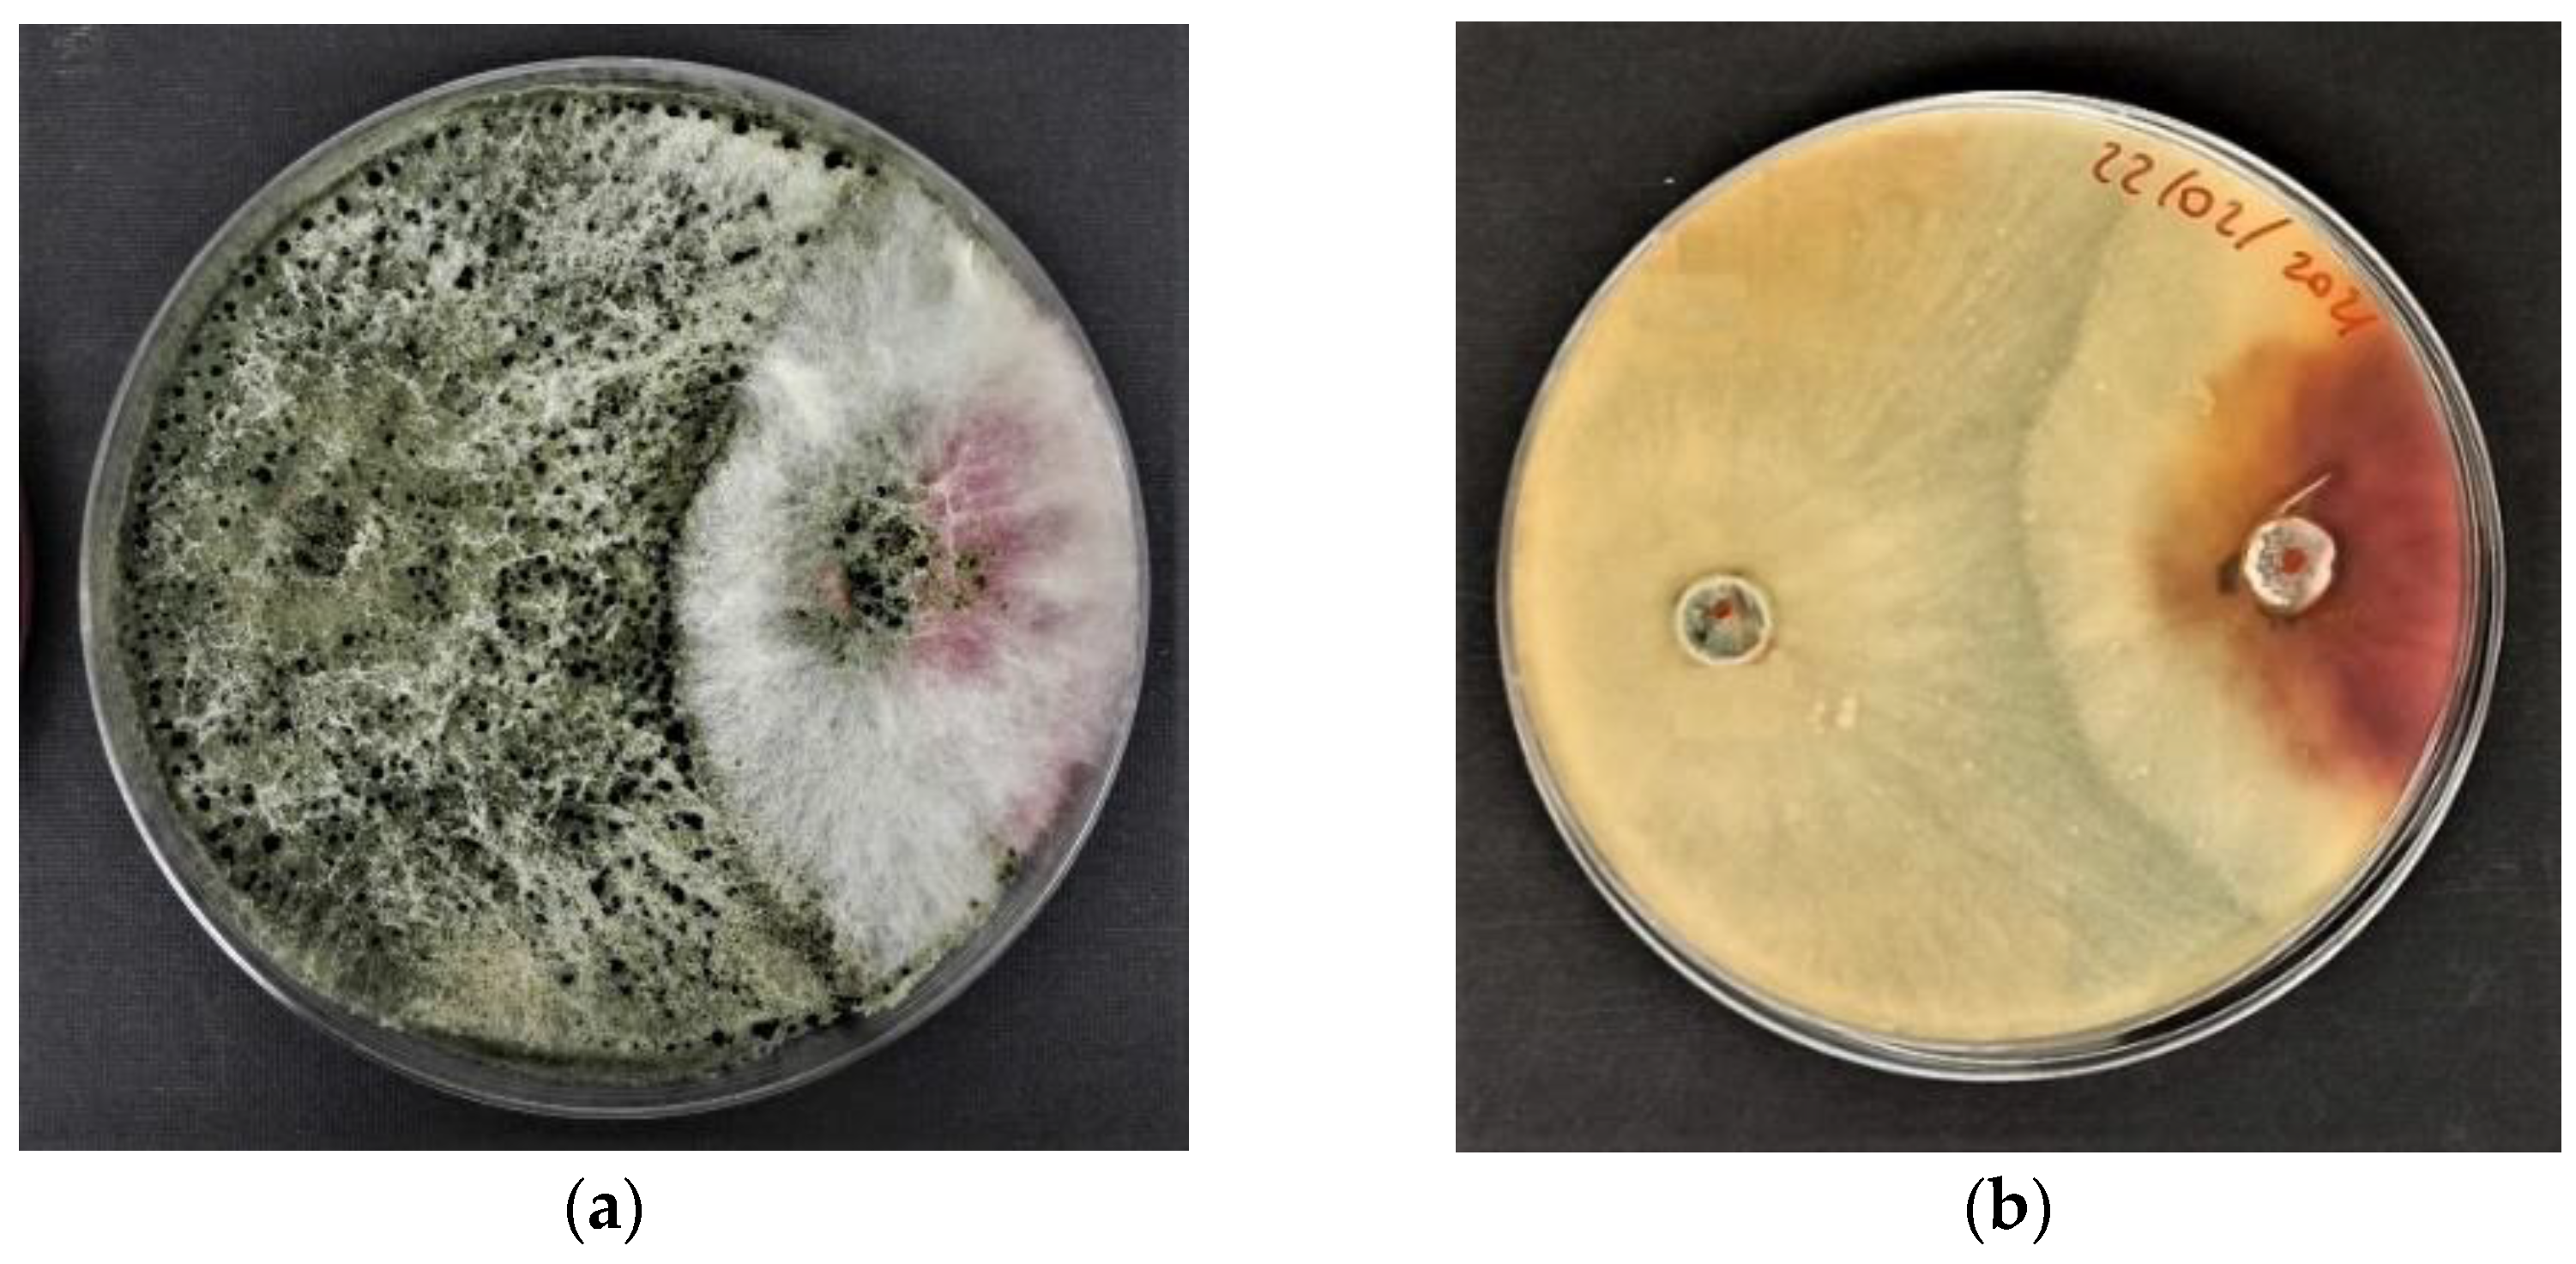
Agriculture 12 00714 g001

Seed Coating with Trichoderma harzianum T-22 of Italian Durum Wheat Increases Protection against Fusarium culmorum-Induced Crown Rot
Abstract
:1. Introduction
2. Materials and Methods
2.1. Inoculum Preparation
2.2. Trichoderma Strain
2.3. In vitro Antagonistic Activity of T. harzianum T-22 against F. culmorum
2.4. Plant Experiment
2.4.1. Plant Material
2.4.2. T. harzianum T-22 Seed Coating Treatment and F. culmorum Inoculation
2.4.3. Effect of T. harzianum T-22 Seed Coating Treatment on Seed Germination and Seedling Growth
2.4.4. Effect of T. harzianum T-22 Seed Coating Treatment on F. culmorum Disease Control
2.5. Statistical Analyses
3. Results
3.1. Antagonistic Activity of Trichoderma harzianum T-22 in Fusarium culmorum Mycelium
3.2. Effect of Seed Coating Treatment on Germination and Seedling Growth
3.3. Root Colonization by T. harzianum T-22
3.4. Effect of Seed Coating with T. harzianum T-22 on Disease Control
4. Discussion
Author Contributions
Funding
Institutional Review Board Statement
Informed Consent Statement
Data Availability Statement
Acknowledgments
Conflicts of Interest
References
- Royo, C.; Soriano, J.M.; Alvaro, F. Wheat: A Crop in the Bottom of the Mediterranean Diet Pyramid. In Mediterranean Identities—Environment, Society, Culture; IntechOpen: London, UK, 2017. [Google Scholar] [CrossRef] [Green Version]
- Kashyap, P.L.; Kumar, S.; Aggarwal, S.K.; Kaul, N.; Jasrotia, P.; Gupta, A.; Singh, G.P. Resistance inducers and their role in reinforcing wheat defense system against fungal pathogens. J. Cereal Res. 2021, 13, 229–254. [Google Scholar] [CrossRef]
- Petti, C.; Reiber, K.; Ali, S.S.; Berney, M.; Doohan, F.M. Auxin as a player in the biocontrol of Fusarium head blight disease of barley and its potential as a disease control agent. BMC Plant Biol. 2012, 12, 1–9. [Google Scholar] [CrossRef] [PubMed] [Green Version]
- Mohapatra, S.; Mittra, B. Alleviation of Fusarium oxysporum induced oxisative stress in wheat by Trichoderma viridae. Arch. Phytopathol. Pflanzenschult 2017, 50, 84–86. [Google Scholar] [CrossRef]
- Pastuszak, J.; Szczerba, A.; Dziurka, M.; Hornyák, M.; Kopeć, P.; Szklarczyk, M.; Płażek, A. Physiological and Biochemical Response to Fusarium culmorum Infection in Three Durum Wheat Genotypes at Seedling and Full Anthesis Stage. Int. J. Mol. Sci. 2021, 22, 7433. [Google Scholar] [CrossRef]
- Jin, J.; Duan, S.; Qi, Y.; Yan, S.; Li, W.; Li, B.; Xie, C.; Zhen, W.; Ma, J. Identification of a novel genomic region associated with resistance to Fusarium crown rot in wheat. Theor. Appl. Genet. 2020, 133, 2063–2073. [Google Scholar] [CrossRef]
- Bouanaka, H.; Bellil, I.; Khelifi, D. Multiple methods for varietal resistance assessment of durum wheat cultivars against Fusarium culmorum the causal agent of Fusarium head blight and crown in Algeria. Physiol. Mol. Plant. Pathol. 2021, 115, 101683. [Google Scholar] [CrossRef]
- Tini, F.; Beccari, G.; Onofri, A.; Ciavatta, E.; Gardiner, D.M.; Covarelli, L. Fungicides may have differential efficacies towards the main causal agents of Fusarium head blight of wheat. Pest Manag. Sci. 2020, 76, 3738–3748. [Google Scholar] [CrossRef]
- Kthiri, Z.; Jabeur, M.B.; Harbaoui, K.; Karmous, C.; Chamekh, Z.; Chairi, F.; Serret, M.D.; Araus, J.L.; Hamada, W. Comparative Performances of Beneficial Microorganisms on the Induction of Durum Wheat Tolerance to Fusarium Head Blight. Microorganisms 2021, 9, 2410. [Google Scholar] [CrossRef]
- Modrzewska, M.; Bryła, M.; Kanabus, J.; Pierzgalski, A. Trichoderma as a biostimulator and biocontrol agent against Fusarium in the production of cereal crops: Opportunities and possibilities. Plant Pathol. 2022, 1–15. [Google Scholar] [CrossRef]
- Harman, G.; Khadka, R.; Doni, F.; Uphoff, N. Benefits to plant health and productivity from enhancing plant microbial symbionts. Front. Plant Sci. 2021, 11, 610065. [Google Scholar] [CrossRef]
- Harman, G.E.; Howell, C.R.; Viterbo, A.; Chet, I.; Lorito, M. Trichoderma species—opportunistic, avirulent plant symbionts. Nat. Rev. Microbiol. 2004, 2, 43–56. [Google Scholar] [CrossRef]
- Woo, S.; Ruocco, M.; Vinale, F.; Nigro, M.; Marra, R.; Lombardi, N.; Pascale, A.; Lanzuise, S.; Manganiello, G.; Lorito, M. Trichoderma-based products and their widespread use in agriculture. Open Mycol. J. 2014, 8, 71–126. [Google Scholar] [CrossRef] [Green Version]
- Vitti, A.; Sofo, A.; Scopa, A.; Nuzzaci, M. Sustainable agricultural practices in disease defence of traditional crops in Southern Italy: The case study of tomato cherry protected by Trichoderma harzianum T-22 Against Cucumber Mosaic Virus (CMV). In The Sustainability of Agro-Food and Natural Resource Systems in the Mediterranean Basin; Vastola, A., Ed.; Springer: Berlin/Heidelberg, Germany, 2015; pp. 133–143. [Google Scholar]
- Sarrocco, S.; Vannacci, G. Preharvest application of beneficial fungi as a strategy to prevent postharvest mycotoxin contamination: A review. Crop. Prot. 2018, 110, 160–170. [Google Scholar] [CrossRef]
- Kthiri, Z.; Jabeur, M.B.; Machraoui, M.; Gargouri, S.; Hiba, K.; Hamada, W. Coating seeds with Trichoderma strains promotes plant growth and enhance the systemic resistance against Fusarium crown rot in durum wheat. Egypt J. Biol. Pest Control 2020, 30, 1–10. [Google Scholar] [CrossRef]
- Xynias, I.N.; Mylonas, I.; Korpetis, E.G.; Ninou, E.; Tsaballa, A.; Avdikos, I.D.; Mavromatis, A.G. Durum Wheat Breeding in the Mediterranean Region: Current Status and Future Prospects. Agronomy 2020, 10, 432. [Google Scholar] [CrossRef] [Green Version]
- Bentivenga, G.; Spina, A.; Ammar, K.; Allegra, M.; Cacciola, S.O. Screening of Durum Wheat (Triticum turgidum L. subsp. durum (Desf.) Husn.) Italian Cultivars for Susceptibility to Fusarium Head Blight Incited by Fusarium graminearum. Plants 2021, 10, 68. [Google Scholar] [CrossRef]
- Bochicchio, R.; Labella, R.; Vitti, A.; Nuzzaci, M.; Logozzo, G.; Amato, M. Root Morphology, Allometric Relations and Rhizosheath of Ancient and Modern Tetraploid Wheats (Triticum durum Desf.) in Response to Inoculation with Trichoderma harzianum T-22. Plants 2022, 11, 159. [Google Scholar] [CrossRef]
- Anselmi, N.; Nicolotti, G.; Sanguinetti, G. Antagonismo in vitro di Trichoderma spp. contro Basidiomycetes agenti di marciumi radicali di piante forestali. Monti e Boschi 1992, 2, 57–59. [Google Scholar]
- Badalyan, S.M.; Innocenti, G.; Garibyan, N.G. Antagonistic Activity of Xylotrophic Mushrooms against Pathogenic Fungi of Cereals in Dual Culture. Phytopathol. Mediterr. 2002, 41, 220–225. [Google Scholar]
- Orzali, L.; Forni, C.; Riccioni, L. Effect of chitosan seed treatment as elicitor of resistance to Fusarium graminearum in wheat. Seed Sci. Technol. 2014, 42, 132–149. [Google Scholar] [CrossRef]
- Arici, S.E. Screening of wheat varieties for their susceptibility against Fusarium crown rot. J. Food Agric. Environ. 2012, 10, 404–408. [Google Scholar]
- Maguire, J.D. Speed of germination-Aid in selection and evaluation for seedling emergence and vigor. Crop. Sci. 1962, 2, 176–177. [Google Scholar] [CrossRef]
- Köycü, N.D. Effect on Fusarium culmorum of fungicides used in Wheat seed. In Proceedings of the International Congress on Engineering and Life Science, Kastamonu, Turkey, 26–29 April 2018; Kastamonu University: Kastamonu, Turkey, 2019; pp. 593–601. [Google Scholar]
- McKinney, H.H. Infuence of soil temperature and moisture on infection of wheat seedlings by Helminthosporium sativum. J. Agric. Res. 1923, 26, 195–217. [Google Scholar]
- Redda, E.T.; Ma, J.; Mei, J.; Li, M.; Wu, B.; Jiang, X. Antagonistic potential of different isolates of Trichoderma against Fusarium oxysporum, Rhizoctonia solani and Botrytis cinereal. Eur. J. Exp. Biol. 2018, 8, 1–12. [Google Scholar] [CrossRef]
- Mironenka, J.; Różalska, S.; Soboń, A.; Bernat, P. Trichoderma harzianum metabolites disturb Fusarium culmorum metabolism: Metabolomic and proteomic studies. Microbiol. Res. 2021, 249, 126770. [Google Scholar] [CrossRef]
- Li, Y.; Sun, R.; Yu, J.; Saravanakumar, K.; Chen, J. Antagonistic and biocontrol potential of Trichoderma asperellum zjsx5003 against the maize stalk rot pathogen Fusarium graminearum. Indian J. Microbiol. 2016, 56, 318–327. [Google Scholar] [CrossRef] [Green Version]
- Stoppacher, N.; Kluger, B.; Zeilinger, S.; Krska, R.; Schuhmacher, R. Identification and profiling of volatile metabolites of the biocontrol fungus Trichoderma atroviride by HS-SPME-GC-MS. J. Microbiol. Methods 2010, 81, 187–193. [Google Scholar] [CrossRef]
- Vinale, F.; Sivasithamparam, K.; Ghisalberti, E.L.; Marra, R.; Barbetti, M.J.; Li, H.; Woo, S.L.; Lorito, M. A novel role for Trichoderma secondary metabolites in the interactions with plants. Physiol. Mol. Plant Pathol. 2008, 72, 80–86. [Google Scholar] [CrossRef]
- Zheng, Z.; Shetty, K. Enhancement of pea (Pisum sativum) seedling vigour and associated phenolic content by extractsof apple pomace fermented with Trichoderma spp. Process. Biochem. 2000, 36, 79–84. [Google Scholar] [CrossRef]
- Celar, F.; Valič, N. Effects of Trichoderma spp. and Gliocladium roseum culture filtrates on seed germination of vegetables and maize. J. Plant Dis. Prot. 2005, 112, 343–350. [Google Scholar]
- Harman, G.E. Overview of mechanisms and uses of Trichoderma spp. Phytopathology 2006, 96, 90–194. [Google Scholar] [CrossRef] [PubMed] [Green Version]
- Vrabka, J.; Niehaus, E.-M.; Münsterkötter, M.; Proctor, R.H.; Brown, D.W.; Novák, O.; Pěnčik, A.; Tarkowská, D.; Hromadová, K.; Hradilová, M. Production and role of hormones during interaction of Fusarium species with maize (Zea mays L.) seedlings. Front. Plant Sci. 2019, 9, 1936. [Google Scholar] [CrossRef] [PubMed]
- Contreras-Cornejo, H.; Macías-Rodríguez, L.I.; Alfaro, C.R.; López-Bucio, J. Trichoderma spp. Improve growth of Arabidopsis seedlings under salt stress through enhanced root development, osmolite production, and Na⁺ elimination through root exudates. Mol. Plant Microbe Interact. 2014, 27, 503–514. [Google Scholar] [CrossRef] [PubMed] [Green Version]
- Cai, F.; Yu, G.; Wang, P.; Wei, Z.; Fu, L.; Shen, Q.; Chen, W. Harzianolide, a novel plant growth regulator and systemic resistance elicitor from Trichoderma harzianum. Plant Physiol. Biochem. 2013, 73, 106–113. [Google Scholar] [CrossRef]
- Vinale, F.; Nigro, N.; Sivasithamparam, K.; Flematti, G.; Ghisalberti, E.L.; Ruocco, M.; Varlese, R.; Marra, R.; Lanzuise, S.; Eid, A.; et al. Harzianic acid: A novel siderophore from Trichoderma harzianum. FEMS Microbiol. Lett. 2013, 347, 123–129. [Google Scholar] [CrossRef] [Green Version]
- Lombardi, N.; Vitale, S.; Turrà, D.; Reverberi, M.; Fanelli, C.; Vinale, F.; Marra, R.; Ruocco, M.; Pascale, A.; d’Errico, G.; et al. Root Exudates of Stressed Plants Stimulate and Attract Trichoderma Soil Fungi. Mol. Plant Microbe Interact. 2018, 31, 982–994. [Google Scholar] [CrossRef] [Green Version]
- Gruet, C.; Muller, D.; Moënne-Loccoz, Y. Significance of the Diversification of Wheat Species for the Assembly and Functioning of the Root-Associated Microbiome. Front. Microbiol. 2022, 12, 782135. [Google Scholar] [CrossRef]
- Iannucci, A.; Canfora, L.; Nigro, F.; De Vita, P.; Beleggia, R. Relationships between root morphology, root exudate compounds and rhizosphere microbial community in durum wheat. Appl. Soil Ecol. 2021, 158, 103781. [Google Scholar] [CrossRef]

| Abbreviation | Genotype | Type | Year of Release | Susceptibility to Fusariosis |
|---|---|---|---|---|
| Cic | Ciclope | Variety (modern) | 2006 | unknown |
| Cre | Creso | Variety (modern) | 1974 | high |
| Sim | Simeto | Variety (modern) | 1988 | high |
| SaL | Saragolle Lucana | Landrace (ancient) | 2014 1 | moderate |
| Inhibition (%) | |||
|---|---|---|---|
| 2 Days | 7 Days | 14 Days | |
| T-22 | 15.43 ± 1.03 | 32.91 ± 1.08 | 51.13 ± 1.38 |
| F. culmorum | 4.95 ± 0.73 | 3.78 ± 1.32 | 2.13 ± 1.00 |
| ANOVA | |||
| Treatments | 1897.74 *** | 846.27 *** | 11345.10 *** |
| Variety | Treatment * | G4 * | G8 * | G12 * | Vigor Index |
|---|---|---|---|---|---|
| Ciclope | Control | 2.6 ± 1.67 a | 9.0 ± 1.87 ab | 15.2 ± 1.30 a | 2.95 ± 016 a |
| T-22 | 6.6 ± 3.78 a | 12.4 ± 4.28 a | 16.0 ± 2.45 a | 3.12 ± 0.34 a | |
| F. culmorum | 2.0 ± 1.22 a | 3.4 ± 0.89 c | 4.8 ± 0.84 b | 0.82 ± 0.09 c | |
| T-22/F. culmorum | 2.2 ± 2.39 a | 5.2 ± 1.64 bc | 6.4 ± 1.95 b | 1.46 ± 0.21 b | |
| Creso | Control | 4.2 ± 4.76 a | 14.4 ± 3.13 a | 17.6 ± 1.52 a | 3.67 ± 0.32 b |
| T-22 | 8.0 ± 3.08 a | 15.8 ± 5.31 a | 18.6 ± 1.95 a | 4.09 ± 0.23 a | |
| F. culmorum | 2.6 ± 0.89 a | 5.6 ± 2.41 b | 7.0 ± 2.45 b | 0.90 ± 0.10 d | |
| T-22/F. culmorum | 3.4 ± 1.14 a | 8.6 ± 4.93 b | 9.4 ± 5.13 b | 2.15 ± 0.11 c | |
| Simeto | Control | 6.0 ± 4.47 a | 11.0 ± 1.00 a | 15.4 ± 1.52 ab | 2.81 ± 0.19 a |
| T-22 | 7.0 ± 5.24 a | 13.0 ± 4.06 a | 18.4 ± 1.14 a | 3.04 ± 0.29 a | |
| F. culmorum | 7.2 ± 1.92 a | 8.4 ± 1.14 a | 10.4 ± 4.72 b | 2.09 ± 0.12 b | |
| T-22/F. culmorum | 9.2 ± 4.92 a | 11.6 ± 3.13 a | 11.8 ± 3.35 b | 2.87 ± 0.25 a | |
| Saragolle Lucana | Control | 14.4 ± 2.61 a | 17.2 ± 2.59 a | 18.6 ± 1.14 a | 3.58 ± 0.29 b |
| T-22 | 14.4 ± 2.61 a | 17.8 ± 1.48 a | 18.6 ± 1.14 a | 3.98 ± 0.37 b | |
| F. culmorum | 9.0 ± 5.96 a | 10.8 ± 5.36 b | 12.8 ± 6.83 a | 2.52 ± 0.33 c | |
| T-22/F. culmorum | 13.2 ± 6.61 a | 14.8 ± 5.89 ab | 14.8 ± 5.89 a | 4.70 ± 0.26 a |
| Variety | Treatment * | Height (cm) | Main Root Length (cm) |
|---|---|---|---|
| Ciclope | Control | 26.27 ± 2.64 b | 19.01 ± 4.86 c |
| T-22 | 29.36 ± 2.62 a | 28.97 ± 3.86 a | |
| F. culmorum | 19.48 ± 4.40 c | 13.07 ± 4.59 d | |
| T-22/F. culmorum | 26.42 ± 5.09 b | 24.93 ± 3.08 b | |
| Creso | Control | 25.31 ± 2.37 b | 18.03 ± 3.94 c |
| T-22 | 27.68 ± 3.27 a | 21.69 ± 3.87 b | |
| F. culmorum | 21.61 ± 3.77 c | 16.01 ± 5.00 d | |
| T-22/F. culmorum | 26.01 ± 2.47 b | 23.97 ± 2.42 a | |
| Simeto | Control | 23.77 ± 2.35 b | 18.19 ± 3.70 c |
| T-22 | 28.11 ± 2.51 a | 26.32 ± 3.25 a | |
| F. culmorum | 19.19 ± 4.05 c | 8.64 ± 2.43 d | |
| T-22/F. culmorum | 27.52 ± 3.67 a | 23.09 ± 4.52 b | |
| Saragolle Lucana | Control | 28.50 ± 3.87 b | 19.11 ± 4.73 b |
| T-22 | 33.19 ± 4.10 a | 24.76 ± 4.84 a | |
| F. culmorum | 17.95 ± 5.14 c | 10.36 ± 4.15 c | |
| T-22/F. culmorum | 27.91 ± 3.77 b | 23.25 ± 3.96 a |
| Variety | Treatment | DI (%) | DSI (%) |
|---|---|---|---|
| Ciclope | F. culmorum | 100.00 ± 0.00 a | 75.13 ± 10.81 a |
| T-22/F. culmorum | 56.67 ± 9.13 b | 54.17 ± 9.20 b | |
| Creso | F. culmorum | 85.33 ± 20.22 a | 45.28 ± 5.50 a |
| T-22/F. culmorum | 43.33 ± 25.28 b | 34.43 ± 4.39 b | |
| Simeto | F. culmorum | 75.00 ± 5.89 a | 42.48 ± 2.48 a |
| T-22/F. culmorum | 56.76 ± 7.08 b | 33.14 ± 2.34 b | |
| Saragolle Lucana | F. culmorum | 93.81 ± 8.52 a | 44.74 ± 3.98 a |
| T-22/F. culmorum | 62.62 ± 7.96 b | 35.96 ± 2.99 b |
Publisher’s Note: MDPI stays neutral with regard to jurisdictional claims in published maps and institutional affiliations. |
© 2022 by the authors. Licensee MDPI, Basel, Switzerland. This article is an open access article distributed under the terms and conditions of the Creative Commons Attribution (CC BY) license (https://creativecommons.org/licenses/by/4.0/).
Share and Cite
Vitti, A.; Bevilacqua, V.; Logozzo, G.; Bochicchio, R.; Amato, M.; Nuzzaci, M. Seed Coating with Trichoderma harzianum T-22 of Italian Durum Wheat Increases Protection against Fusarium culmorum-Induced Crown Rot. Agriculture 2022, 12, 714. https://doi.org/10.3390/agriculture12050714
Vitti A, Bevilacqua V, Logozzo G, Bochicchio R, Amato M, Nuzzaci M. Seed Coating with Trichoderma harzianum T-22 of Italian Durum Wheat Increases Protection against Fusarium culmorum-Induced Crown Rot. Agriculture. 2022; 12(5):714. https://doi.org/10.3390/agriculture12050714
Chicago/Turabian StyleVitti, Antonella, Vincenzo Bevilacqua, Giuseppina Logozzo, Rocco Bochicchio, Mariana Amato, and Maria Nuzzaci. 2022. "Seed Coating with Trichoderma harzianum T-22 of Italian Durum Wheat Increases Protection against Fusarium culmorum-Induced Crown Rot" Agriculture 12, no. 5: 714. https://doi.org/10.3390/agriculture12050714
APA StyleVitti, A., Bevilacqua, V., Logozzo, G., Bochicchio, R., Amato, M., & Nuzzaci, M. (2022). Seed Coating with Trichoderma harzianum T-22 of Italian Durum Wheat Increases Protection against Fusarium culmorum-Induced Crown Rot. Agriculture, 12(5), 714. https://doi.org/10.3390/agriculture12050714

